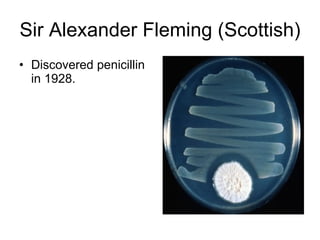
Sir Alexander Fleming (Scottish) Discovered penicillin in 1928.

1) Anaximander developed the theory that humans evolved from fish. Hippocrates was known as the "Father of Modern Medicine" and authored the Hippocratic Oath.
2) Aristotle observed and classified animals and wrote extensively on biology, establishing him as the "Father of biology". Galen established the idea of pulmonary circulation and contributed to experimental physiology.
3) Key figures included Robert Hooke who discovered cells, Edward Jenner who pioneered vaccination, Charles Darwin for his theory of evolution, and Alfred Wallace for independently discovering evolutionary change.



![Hippocrates “ Father of Modern Medicine.” Hippocratic Oath was named for him. Wrote Corpus Hippocraticum The World Medical Association's logo[4] features a serpent wrapped around a staff, the symbol of the ancient Greek god Asklepios. Aesculapius, worshipped by the Greeks as the god of healing, who originated in ancient Egypt as Imhotep, high-priest, sage and minister to the pharaoh, Zoser. It is significant that this symbol is reminiscent of the Staff of Moses.[5] The World Health Organisation's logo[6] also contains the ancient religious symbol of the serpent and staff, which is superimposed over the United Nations emblem.](https://image.slidesharecdn.com/notablebiologists-100613081923-phpapp01/85/Notable-biologists-4-320.jpg)